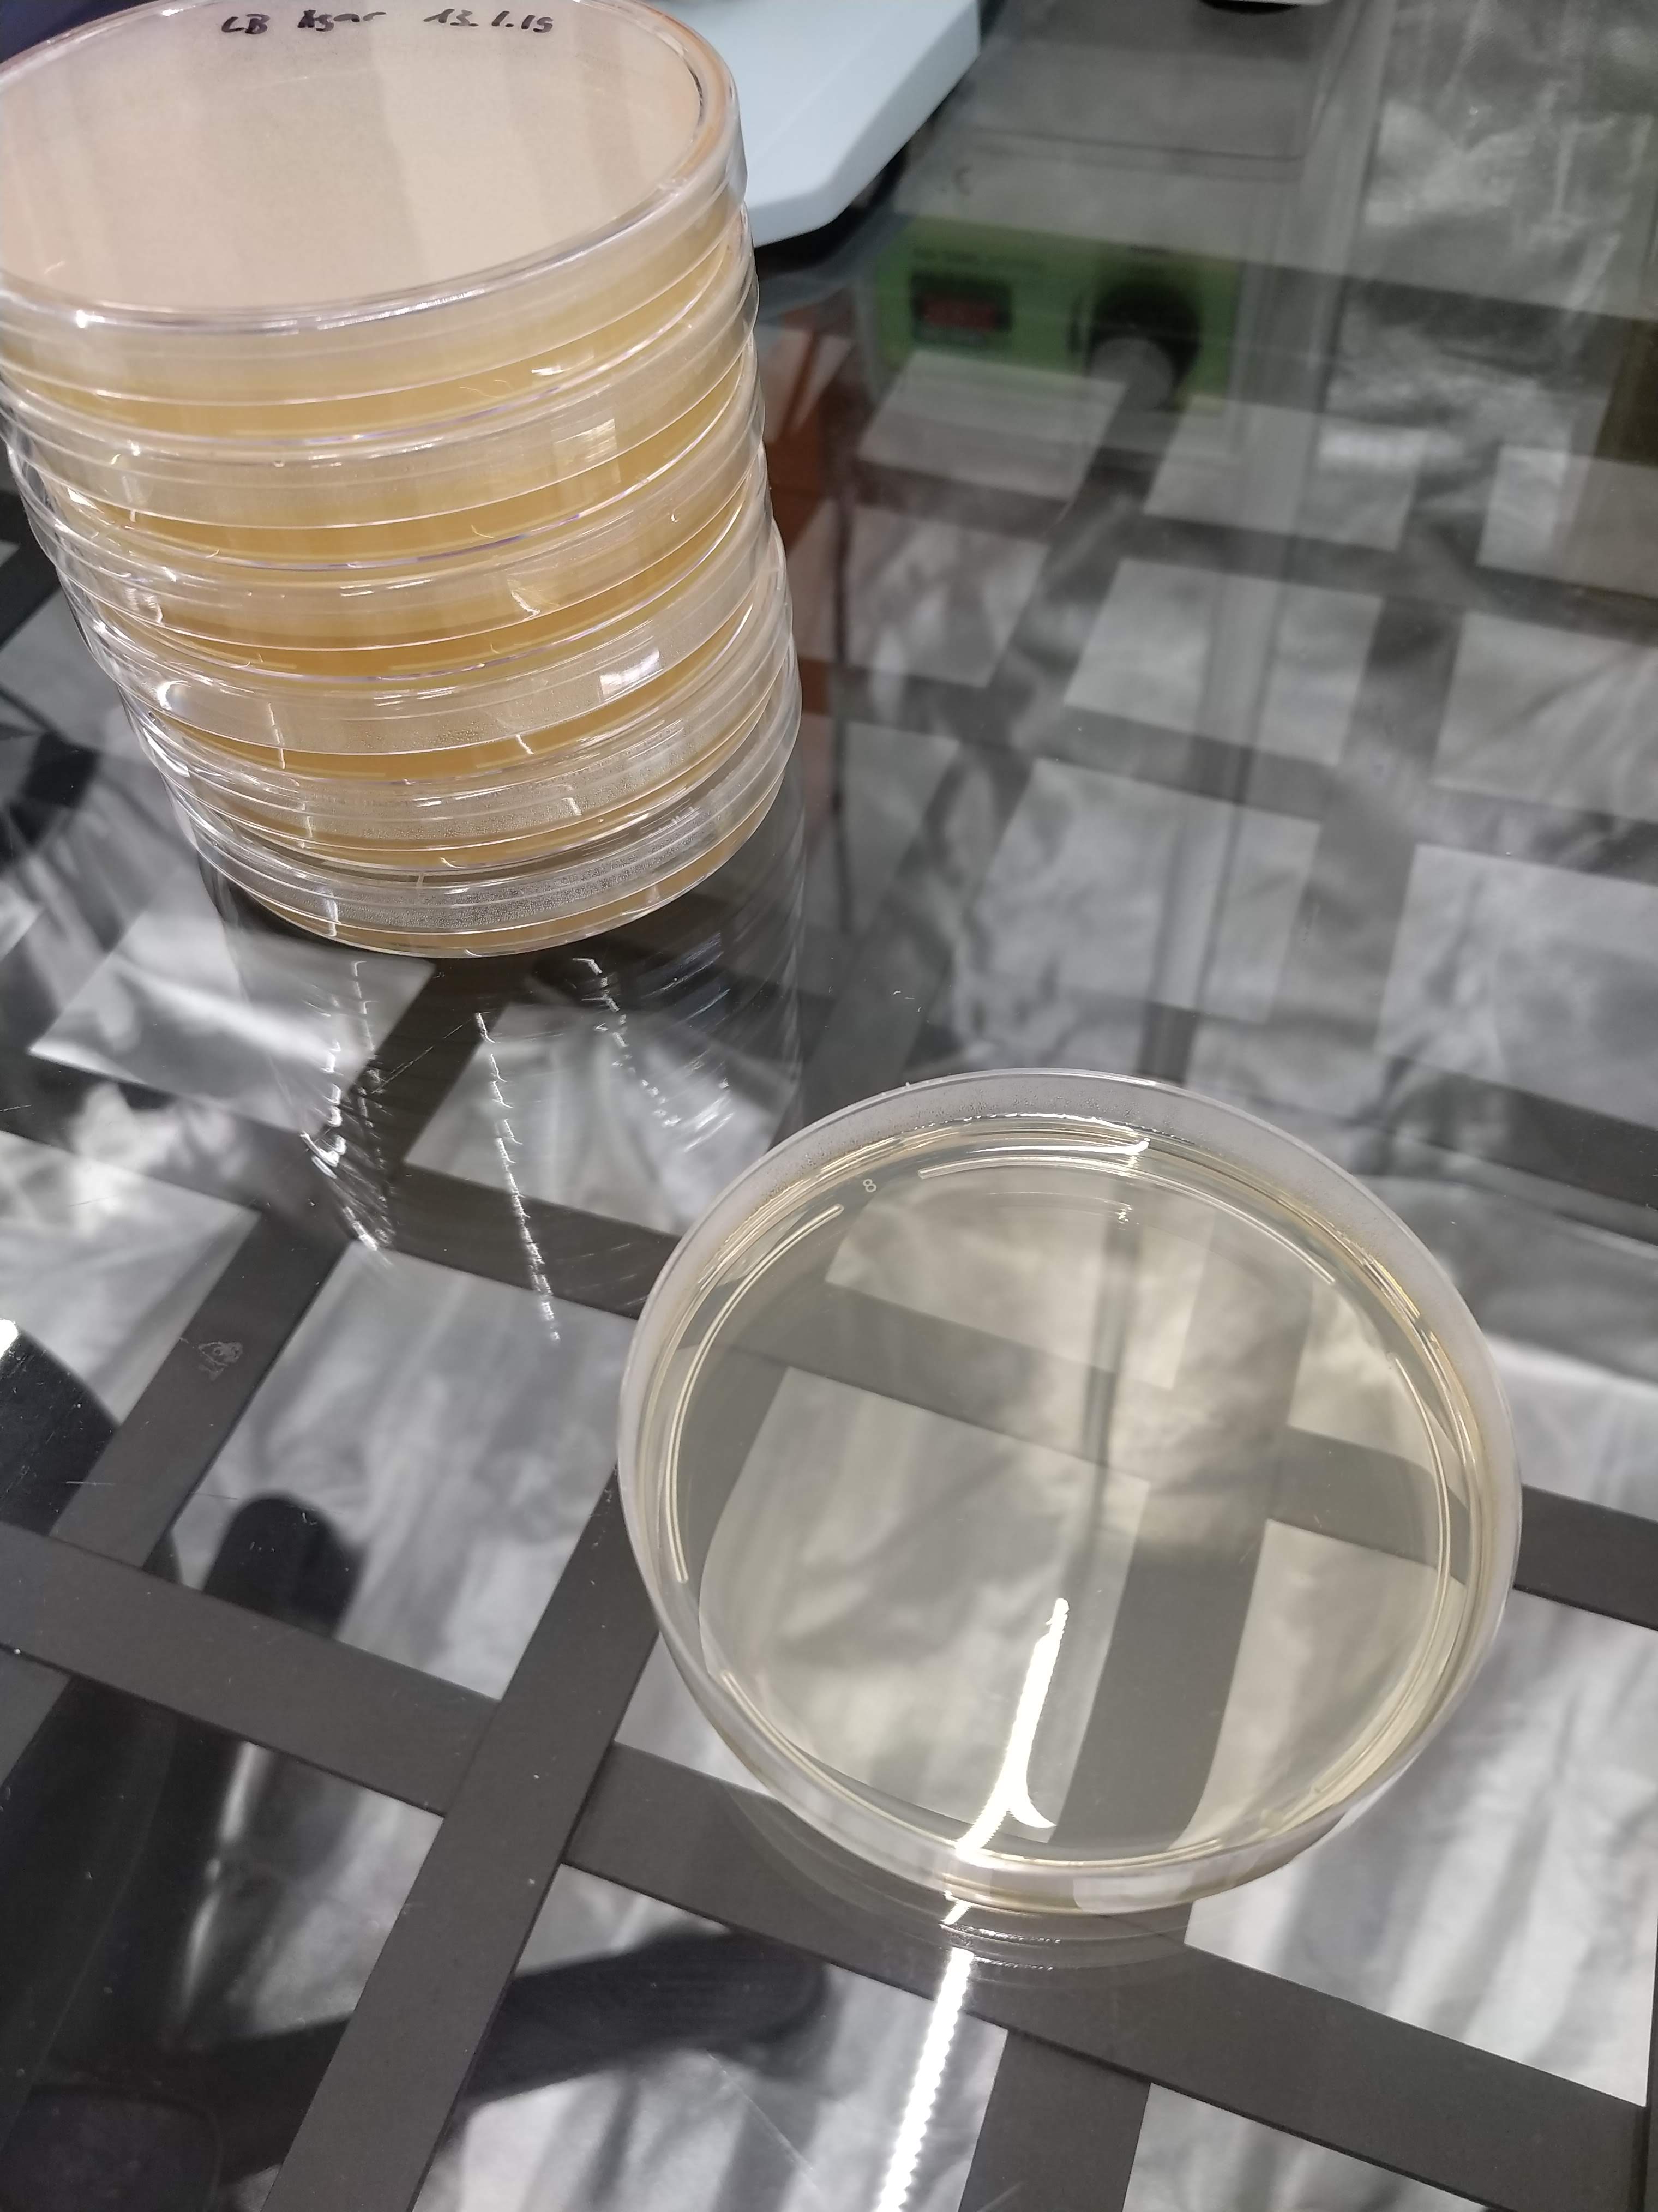
Fertige Pertischalen
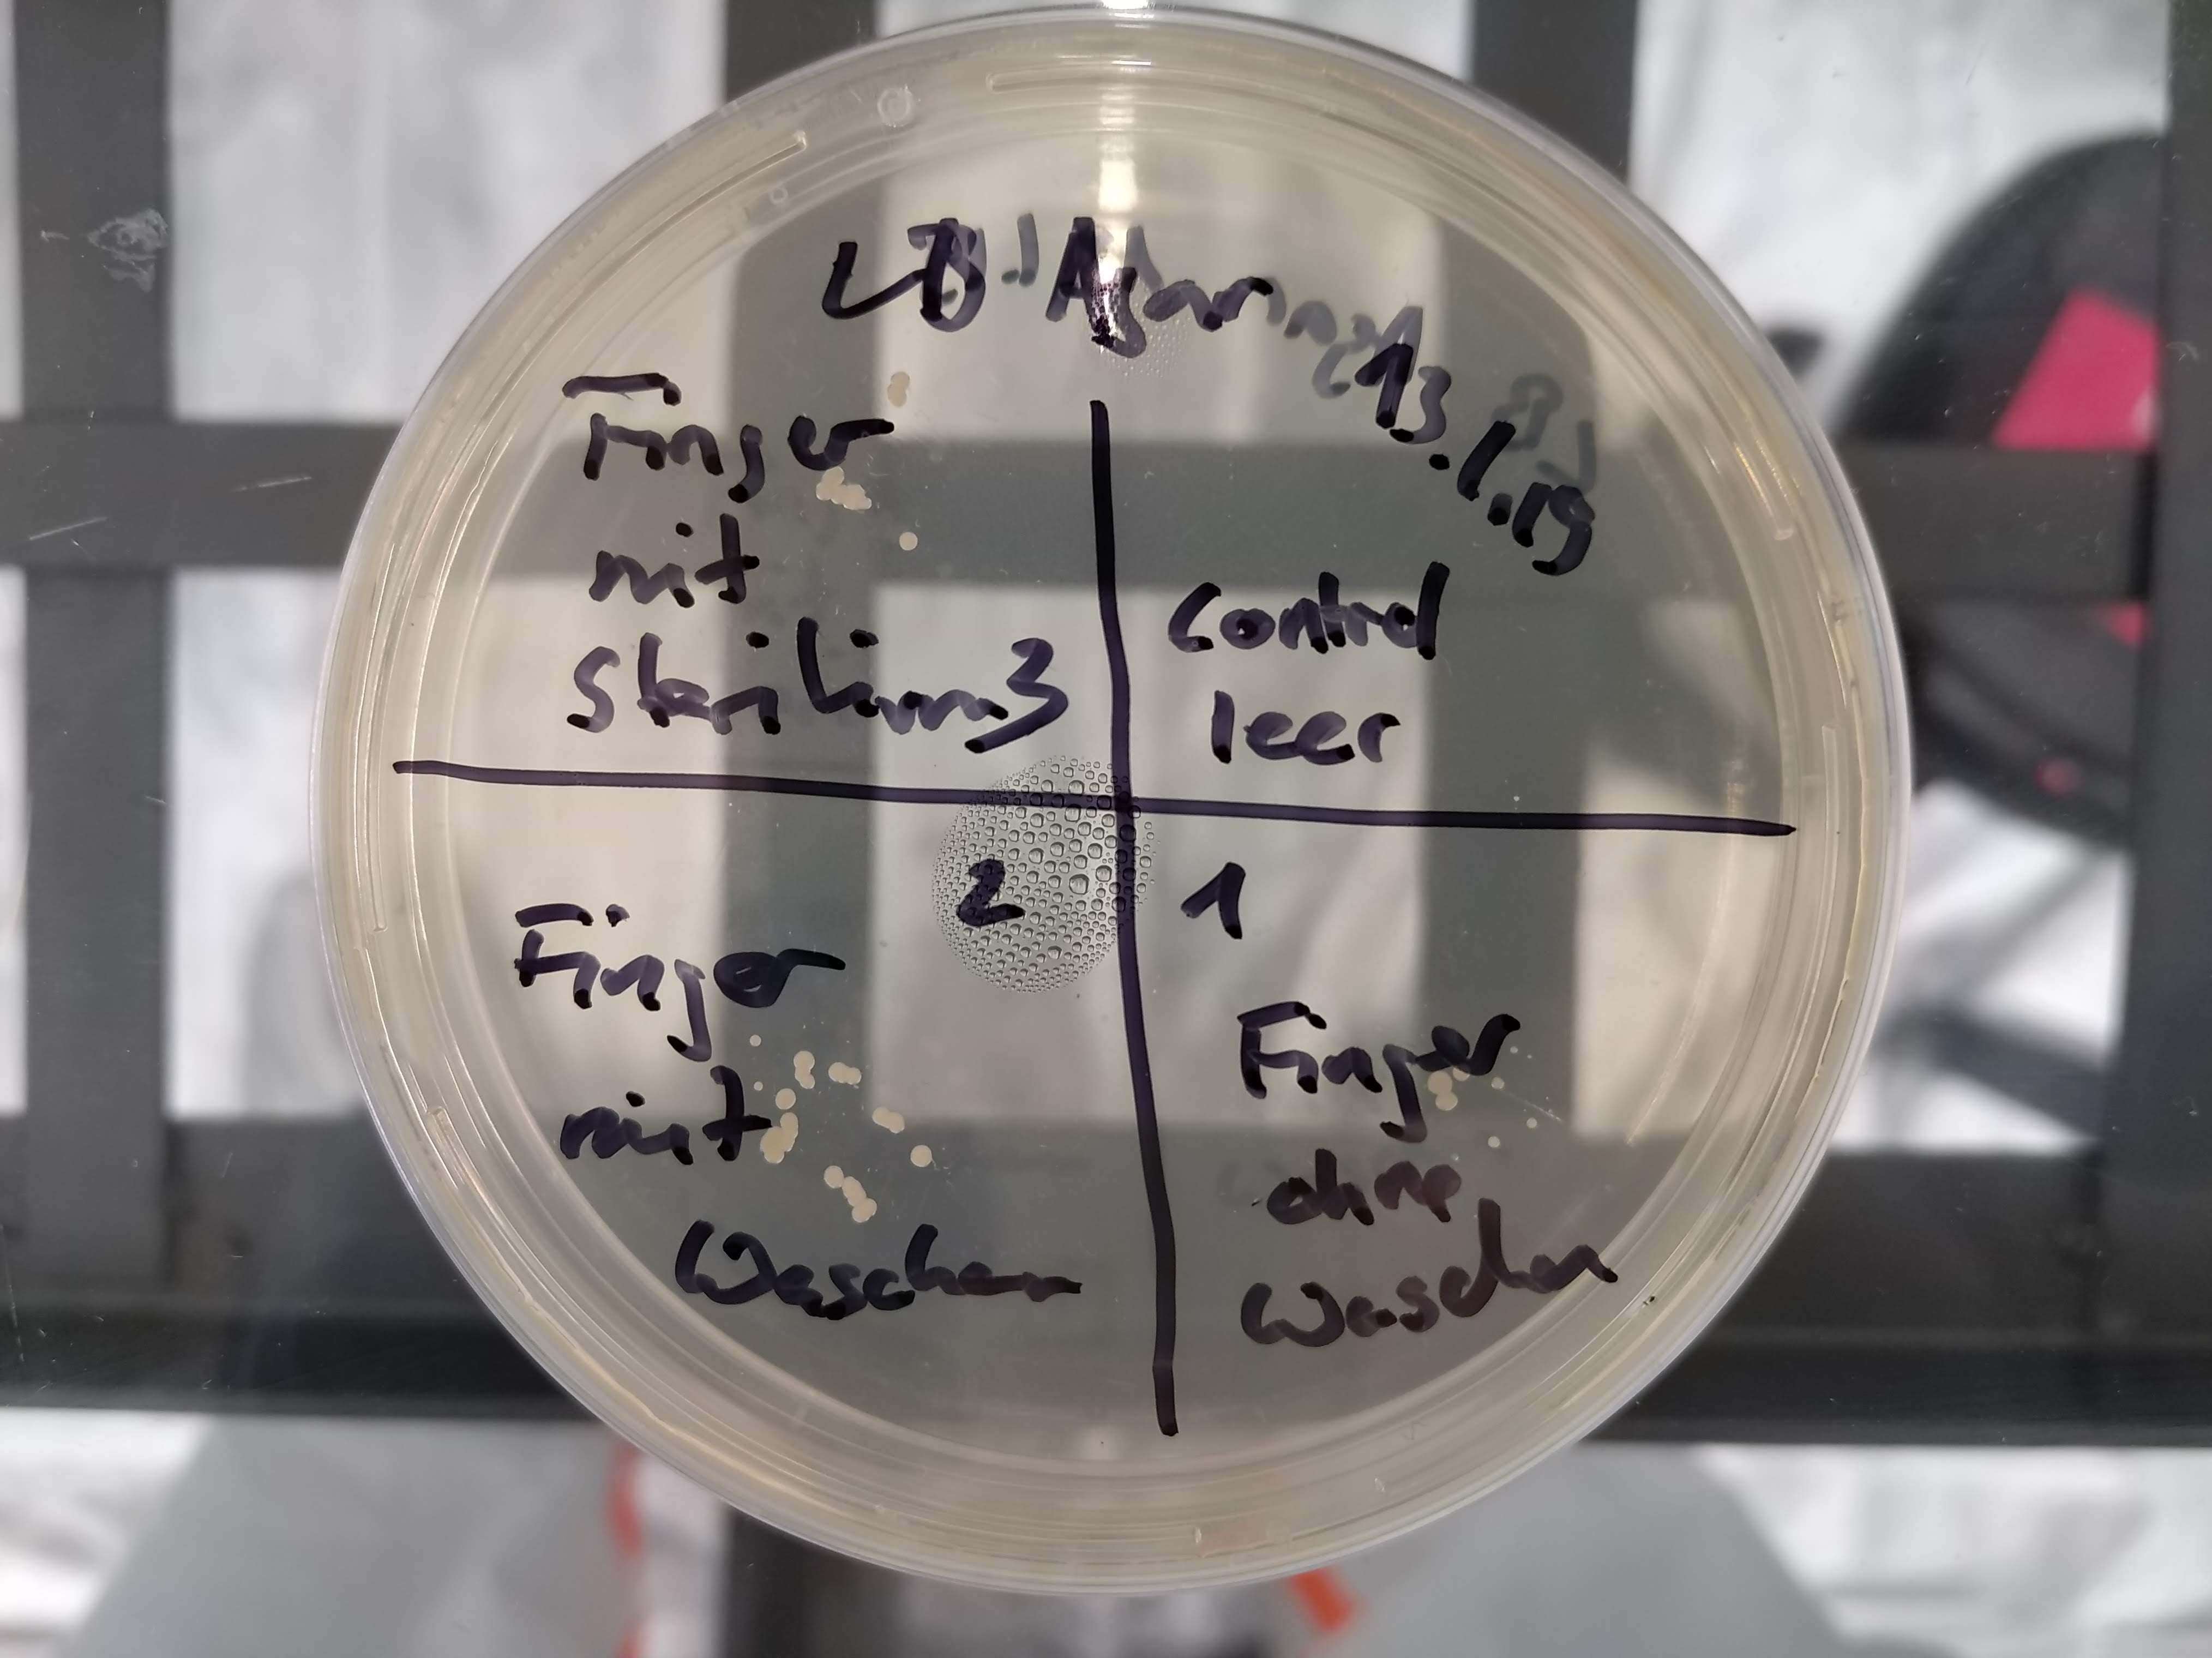
Plate_Finger

Monat 1
Lesestoff:
Kapitel 1 (Zellen und Genome) sowie Kapitel 2 (Zellchemie und Bioenergetik) von "Molekularbiologie der Zelle" sowie die Papers:
- The Developmental Capacity of Nuclei taken from Intestinal Epithelium Cells of Feeding Tadpoles (J. B. Gurdon)
- Measurement Of Current-voltage Relations In The Membrane Of The Giant Axon Of Loligo (A. L. Hodgkin, A. F. Huxley And B. Katz)
- Induction of Pluripotent Stem Cells from Mouse Embryonic and Adult Fibroblast Cultures by Defined Factors (Kazutoshi Takahashi and Shinya Yamanaka)
- Creation of a Bacterial Cell Controlled by a Chemically Synthesized Genome (Daniel G. Gibson)

Hands-On:
Giessen von LB-AGAR Petrischalen:
Nach dem vermischen eines Röhrchens LB-AGAR (ca. 5g) mit 125ml sterilen Wasser wurde das Gemisch in der Mikrowelle sorgfältig aufgeheizt (schäumt beim Sieden) bis sich alles klar gelöst hat.
Danach wurde die Lösung zusätzlich im Autoklaven 20min bei 121°C sterilisiert (Flüssigkeitsprogramm mit Messfühler in 125ml Wasser als Referenz, Flaschendeckel nur aufgelegt!)

Nach Abkühlen auf ca. 50°C wurde die Lösung auf 7 Petrischalen verteilt und aushärten gelassen. Die Platten wurden über Nacht trocknen gelassen und danach in den Kühlschrank bei 4°C bis zur Weiterverwertung gelagert.
Experiment 1 - Fingerabdrücke auf LB-AGAR Petrischale:
Auf den Quadranten der Petrischale sind:
- Rechts-Oben "leeres Kontrollfeld"
- Rechts-Unten "Ungewaschener Fingerabdruck"
- Links-Unten "Finger eingehend mit Seife gewaschen"
- Links-Oben "Finger eingehend mit Desinfektionsmittel (Sterilium) gereinigt"
Danach wurde die Platte 24std bei 38°C inkubiert.
Spannenderweise habe ich den Befund von Josiah Zayner im Biohacker 101 Forum reproduziert, wobei nach dem Fingerwaschen tendenziell eher mehr Keime auf der Platte waren. Völlig erstaunt bin ich vom Ergebnis, dass selbst nach Verwendung von Sterilium Keime übrigbleiben.
Ich plane zu einem späteren Zeitpunkt das Experiment zu wiederholen, die Kolonien zu extrahieren und die Zusammensetzung der 16S Gene zu sequenzieren (ONT Minion) um festzustellen welche Keime hier wachsen..
Experiment 2 - Boden-/Wasserprobe auf Petrischale:
Auf der 2. Platte brachte ich eine Bodenprobe von unserem Gekko (phelsuma), von unseren Zwergziegen sowie eine Wasserprobe vom Salzwasseraquarium auf:
- Rechts-Oben "leeres Kontrollfeld"
- Rechts-Unten "Bodenprobe Zwergziegen"
- Links-Unten "Tropfen vom Salzwasseraquarium"
- Links-Oben "Bodenprobe Gekko"
Die Platte wurde 24std bei 38°C inkubiert.

Ich habe die Kulturen unter meinem guten alten Nikon Mikroskop näher angesehen:
Vom Aquarienwasser:
Zweites vom Zwergziegenboden (Könnte ein Pilz sein?)
Und die letzten 2 vom Gekko-boden:
Hat jemand eine Ahnung was wir hier sehen? Gerne Feedback über das Kontaktformular :-)